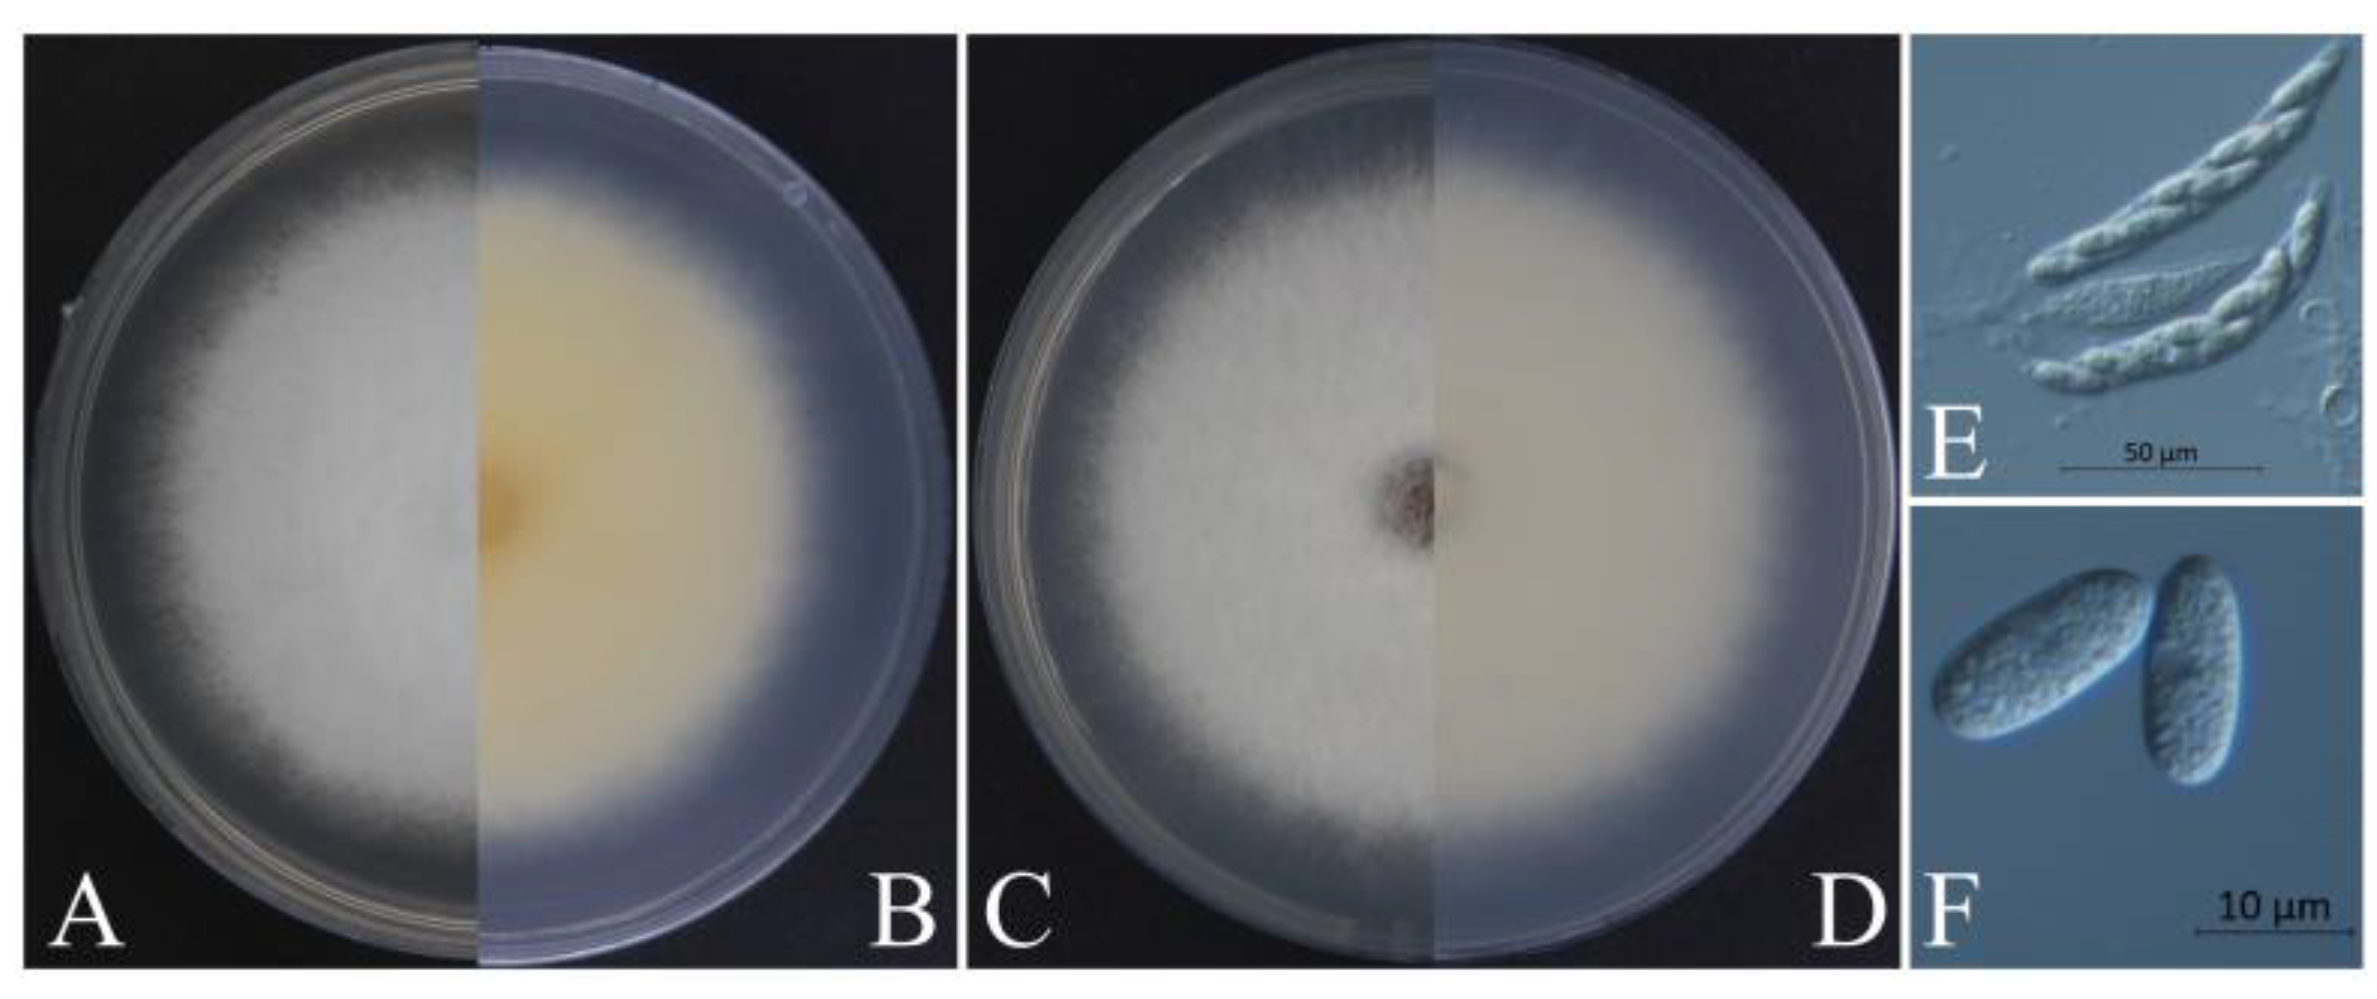

Species of the Colletotrichum spp., the Causal Agents of Leaf Spot on European Hornbeam (Carpinus betulus)
Abstract
1. Introduction
2. Materials and Methods
2.1. Sampling and Fungal Isolation
2.2. Pathogenicity Tests
2.3. Morphological Characteristics
2.4. Phylogenetic Analysis
3. Results
3.1. Field Survey and Symptoms in the Field
3.2. Fungal Isolation
3.3. Morphological Characteristics
3.4. Pathogenicity Tests
3.5. Phylogenetic Analysis
4. Discussion
5. Conclusions
Author Contributions
Funding
Institutional Review Board Statement
Informed Consent Statement
Data Availability Statement
Conflicts of Interest
References
- Abdi, E.; Majnounian, B.; Rahimi, H.; Zobeiri, M. Distribution and tensile strength of Hornbeam (Carpinus betulus) roots growing on slopes of Caspian Forests, Iran. J. For. Res. 2009, 20, 105–110. [Google Scholar] [CrossRef]
- Kiaei, M. Effect of site and elevation on wood density and shrinkage and their relationships in Carpinus betulus. For. Stud. China 2012, 14, 229–234. [Google Scholar] [CrossRef]
- Rocchi, F.; Quaroni, S.; Sardi, P.; Saracchi, M. Studies on Anthostoma decipiens involved in Carpinus betulus decline. J. Plant Pathol. 2010, 92, 637–644. [Google Scholar] [CrossRef]
- Cieckiewicz, E.; Angenot, L.; Gras, T.; Kiss, R.; Frédérich, M. Potential anticancer activity of young Carpinus betulus leaves. Phytomedicine 2012, 19, 278–283. [Google Scholar] [CrossRef] [PubMed]
- Sheng, Q.Q.; Fang, X.Y.; Zhu, Z.L.; Xiao, W.; Wang, Z.Z.; Ding, G.; Zhao, L.G.; Li, Y.J.; Yu, P.; Ding, Z.B.; et al. Seasonal variation of pheophorbide a and flavonoid in different organs of two Carpinus species and its correlation with immunosuppressive activity. In Vitro Cell. Dev. Biol. Anim. 2016, 52, 654–661. [Google Scholar] [CrossRef] [PubMed]
- Liu, F.; Ma, Z.; Hou, L.; Diao, Y.; Wu, W.; Damm, U.; Song, S.; Cai, L. Updating species diversity of Colletotrichum, with a phylogenomic overview. Stud. Mycol. 2022, 101, 1–56. [Google Scholar] [CrossRef]
- Dean, R.; Van Kan, J.A.L.; Pretorius, Z.A.; Hammond-Kosack, K.E.; Di Pietro, A.; Spanu, P.D.; Rudd, J.J.; Dickman, M.; Kahmann, R.; Ellis, J.; et al. The Top 10 fungal pathogens in molecular plant pathology. Mol. Plant Pathol. 2012, 13, 414–430. [Google Scholar] [CrossRef]
- Cannon, P.F.; Buddie, A.G.; Bridge, P.D. The typification of Colletotrichum gloeosporioides. Mycotaxon 2008, 104, 189–204. [Google Scholar]
- O’Connell, R.J.; Thon, M.R.; Hacquard, S.; Amyotte, S.G.; Kleemann, J.; Torres, M.F.; Damm, U.; Buiate, E.A.; Epstein, L.; Alkan, N. Lifestyle transitions in plant pathogenic Colletotrichum fungi deciphered by genome and transcriptome analyses. Nat. Genet. 2012, 44, 1060–1065. [Google Scholar] [CrossRef]
- Guarro, J.; Svidzinski, T.E.; Zaror, L.S.; Forjaz, M.H.; Gené, J.; Fischman, O. Subcutaneous hyalohyphomycosis caused by Colletotrichum gloeosporioides. J. Clin. Microbiol. 1998, 36, 3060–3065. [Google Scholar] [CrossRef]
- Shiraishi, A.; Araki-Sasaki, K.; Mitani, A.; Miyamoto, H.; Sunada, A.; Ueda, A.; Asari, S.; Zheng, X.; Yamamoto, Y.; Hara, Y. Clinical characteristics of keratitis due to Colletotrichum gloeosporioides. J. Ocul. Pharmacol. Ther. 2011, 27, 487–491. [Google Scholar] [CrossRef] [PubMed]
- Du, M.; Schardl, C.L.; Nuckles, E.M.; Vaillancourt, L.J. Using mating-type gene sequences for improved phylogenetic resolution of Collectotrichum species complexes. Mycologia 2005, 97, 641–658. [Google Scholar] [CrossRef] [PubMed]
- Damm, U.; Woudenberg, J.H.C.; Cannon, P.F.; Crous, P.W. Colletotrichum species with curved conidia from herbaceous hosts. Fungal Divers. 2009, 39, 45. [Google Scholar] [CrossRef]
- Xiang, M.; Zhang, Y.; Liu, X. Research progress on the taxonomy of Colletotrichum. J. Zhongkai Univ. Agric. Eng. 2017, 30, 59–66. [Google Scholar]
- Bailey, J.A.; O’Connell, R.J.; Pring, R.J. Infection strategies of Colletotrichum species. In Colletotrichum: Biology, Pathology and Control; CAB International: Wallingford, UK, 1992. [Google Scholar]
- Thaung, M.M. Coelomycete systematics with special reference to Colletotrichum. Mycoence 2008, 49, 345–350. [Google Scholar] [CrossRef]
- Sherriff, C.; Whelan, M.J.; Arnold, G.M.; Lafay, J.F.; Brygoo, Y.; Bailey, J.A. Ribosomal DNA Sequence Analysis Reveals New Species Groupings in the Genus Colletotrichum. Exp. Mycol. 1994, 18, 121–138. [Google Scholar] [CrossRef]
- Crouch, J.A.; Clarke, B.B.; White Jr, J.F.; Hillman, B.I. Systematic analysis of the falcate-spored graminicolous Colletotrichum and a description of six new species from warm-season grasses. Mycologia 2009, 101, 717–732. [Google Scholar] [CrossRef]
- Li, N. Study on the Species of Anthracnose Pathogens and the Groups Gegetic Diversity; Sichuan Agricultural University: Chengdu, China, 2012. [Google Scholar]
- Weir, B.S.; Johnston, P.R.; Damm, U. The Colletotrichum gloeosporioides species complex. Stud. Mycol. 2012, 73, 115–180. [Google Scholar] [CrossRef]
- Zhou, Y.; Ye, R.; Ying, Q.; Zhang, Y.; Zhang, L. First Report of Leaf Spot Caused by Colletotrichum fructicola on Dalbergia hupeana in China. Plant Dis. 2022, 106, 1526. [Google Scholar] [CrossRef]
- Prihastuti, H.; Cai, L.; Chen, H.; McKenzie, E.; Hyde, K. Characterization of Colletotrichum species associated with coffee berries in northern Thailand. Fungal Divers 2009, 39, 89–109. [Google Scholar]
- Shu, J.; Ning, P.; Guo, T.; Tang, L.; Huang, S.; Li, Q.; Mo, J.; Yu, Z.; Hsiang, T. First report of leaf spot caused by Colletotrichum fructicola on Callerya speciosa (Millettia speciosa) in Guangxi, China. Plant Dis. 2020, 104, 1–6. [Google Scholar] [CrossRef]
- Meetum, P.; Leksomboon, C.; Kanjanamaneesathian, M. First report of Colletotrichum aenigma and C. siamense, the causal agents of anthracnose disease of dragon fruit in Thailand. J. Plant Pathol. 2015, 97, 402. [Google Scholar] [CrossRef]
- Choi, H.-W.; Lee, Y.; Hong, S. First report of Colletotrichum aenigma causing anthracnose on Sedum kamtschaticum in Korea. Plant Dis. 2017, 101, 2150. [Google Scholar] [CrossRef]
- Yang, S.; Wang, H.; Yi, Y.; Tan, L. First report that Colletotrichum aenigma causes leaf spots on Camellia japonica L. in China. Plant Dis. 2019, 103, 2127. [Google Scholar] [CrossRef]
- Tang, S.-F.; Tan, L.-L. First Report of Colletotrichum gloeosporioides Causing Leaf Spots on Rubia cordifolia in Qingdao, China. Plant Dis. 2020, 104, 2733. [Google Scholar] [CrossRef]
- Riolo, M.; Aloi, F.; Pane, A.; Cara, M.; Cacciola, S.O. Twig and shoot dieback of citrus, a new disease caused by Colletotrichum species. Cells 2021, 10, 449. [Google Scholar] [CrossRef]
- Pacheco-Esteva, M.C.; Soto-Castro, D.; Vásquez-López, A.; Tovar-Pedraza, J.M. First report of Colletotrichum siamense causing papaya anthracnose in Mexico. J. Plant Pathol. 2022, 104, 1175. [Google Scholar] [CrossRef]
- Krishnan, S.; Kaari, M.; Sawhney, S.; Sheoran, N.; Gautam, R.K.; Mohan Das, M.; Kumar, A. First report of Colletotrichum siamense from Andaman and Nicobar Islands causing anthracnose in chilli. J. Plant Pathol. 2019, 101, 767. [Google Scholar] [CrossRef]
- Wang, W.; Zhang, J.; Li, J. First report of Colletotrichum siamense causing stem tip dieback of Sacha Inchi (Plukenetia volubilis) in China. Plant Dis. 2020, 104, 2726. [Google Scholar] [CrossRef]
- Borges, R.C.; Rossato, M.; Santos, M.D.M.; Macedo, M.A.; Fonseca, M.; Boiteux, L.; Reis, A. Colletotrichum siamense as a causal agent of leaf anthracnose in seedlings of Annona muricata in nurseries from the Federal District, Brazil. J. Plant Dis. Prot. 2021, 128, 583–588. [Google Scholar] [CrossRef]
- Piątek, M. First report of powdery mildew (Oidium carpini) on Carpinus betulus in Poland. Plant Pathol. 2004, 53, 246. [Google Scholar] [CrossRef]
- Vajna, L. Powdery mildew caused by Erysiphe carpinicola on Carpinus betulus in Hungary: The first European report. Plant Pathol. 2006, 55, 575. [Google Scholar] [CrossRef]
- Pastircakova, K.; Takamatsu, S.; Shiroya, Y.; Pastircak, M. European hornbeam powdery mildew Erysiphe arcuata in Slovakia. J. Phytopathol. 2008, 156, 597–601. [Google Scholar] [CrossRef]
- Chinan, V.-C.; Mânzu, C.C. First report of Erysiphe arcuata on Carpinus betulus in Romania. J. Plant Pathol. 2021, 103, 405. [Google Scholar] [CrossRef]
- Mao, Y.-F.; Chen, H.; Jin, L.; Wang, M.; Zheng, X.-R.; Chen, F. First Report of Wilt of European Hornbeam (Carpinus betulus) Caused by Fusarium oxysporum in China. Plant Dis. 2021, 105, 3759. [Google Scholar] [CrossRef]
- Xue, L.H.; Zhang, L.; Yang, X.X.; Huang, X.Q.; Wu, W.X.; Zhou, X.Q.; White, J.F.; Liu, Y.; Li, C.J. Characterization, Phylogenetic Analyses, and Pathogenicity of Colletotrichum Species on Morus alba in Sichuan Province, China. Plant Dis. 2019, 103, 2624–2633. [Google Scholar] [CrossRef]
- Huang, L.; Li, Q.C.; Zhang, Y.; Li, D.W.; Ye, J.R. Colletotrichum gloeosporioides sensu stricto Is a Pathogen of Leaf Anthracnose on Evergreen Spindle Tree (Euonymus japonicus). Plant Dis. 2016, 100, 672–678. [Google Scholar] [CrossRef]
- Lin, S.H.; Huang, S.L.; Li, Q.Q.; Hu, C.J.; Fu, G.; Qin, L.P.; Ma, Y.F.; Xie, L.; Cen, Z.L.; Yan, W.H. Characterization of Exserohilum rostratum, a new causal agent of banana leaf spot disease in China. Australas. Plant Pathol. 2011, 40, 246–259. [Google Scholar] [CrossRef]
- White, T.J.; Bruns, T.D.; Lee, S.B.; Taylor, J.W. Amplification and Direct Sequencing of Fungal Ribosomal RNA Genes for Phylogenetics. In PCR—Protocols and Applications—A Laboratory Manual; Innis, M.A., Gelfand, D.H., Sninsky, J.J., White, T.J., Eds.; Academic Press, Inc.: New York, NY, USA, 1990. [Google Scholar]
- Gardes, M.; Bruns, T.D. ITS primers with enhanced specificity for basidiomycetes-application to the identification of mycorrhizae and rusts. Mol. Ecol. 1993, 2, 113–118. [Google Scholar] [CrossRef] [PubMed]
- Templeton, M.D.; Rikkerink, E.H.; Solon, S.L.; Crowhurst, R.N. Cloning and molecular characterization of the glyceraldehyde-3-phosphate dehydrogenase-encoding gene and cDNA from the plant pathogenic fungus Glomerella cingulata. Gene 1992, 122, 225–230. [Google Scholar] [CrossRef]
- O’Donnell, K.; Cigelnik, E. Two divergent intragenomic rDNA ITS2 types within a monophyletic lineage of the fungus Fusarium are nonorthologous. Mol. Phylogenetics Evol. 1997, 7, 103–116. [Google Scholar] [CrossRef] [PubMed]
- Glass, N.L.; Donaldson, G.C. Development of primer sets designed for use with the PCR to amplify conserved genes from filamentous ascomycetes. Appl. Environ. Microbiol. 1995, 61, 1323–1330. [Google Scholar] [CrossRef] [PubMed]
- Carbone, I.; Kohn, L.M. A method for designing primer sets for speciation studies in filamentous ascomycetes. Mycologia 1999, 91, 553–556. [Google Scholar] [CrossRef]
- Stephenson, S.-A.; Green, J.R.; Manners, J.M.; Maclean, D.J. Cloning and characterisation of glutamine synthetase from Colletotrichum gloeosporioides and demonstration of elevated expression during pathogenesis on Stylosanthes guianensis. Curr. Genet. 1997, 31, 447–454. [Google Scholar] [CrossRef] [PubMed]
- Rojas, E.I.; Rehner, S.A.; Samuels, G.J.; Van Bael, S.A.; Herre, E.A.; Cannon, P.; Chen, R.; Pang, J.; Wang, R.; Zhang, Y. Colletotrichum gloeosporioides sl associated with Theobroma cacao and other plants in Panama: Multilocus phylogenies distinguish host-associated pathogens from asymptomatic endophytes. Mycologia 2010, 102, 1318–1338. [Google Scholar] [CrossRef]
- Katoh, K.; Standley, D.M. MAFFT multiple sequence alignment software version 7: Improvements in performance and usability. Mol. Biol. Evol. 2013, 30, 772–780. [Google Scholar] [CrossRef]
- Zhang, D.; Gao, F.; Jakovlić, I.; Zou, H.; Zhang, J.; Li, W.X.; Wang, G.T. PhyloSuite: An integrated and scalable desktop platform for streamlined molecular sequence data management and evolutionary phylogenetics studies. Mol. Ecol. Resour. 2020, 20, 348–355. [Google Scholar] [CrossRef]
- Nguyen, L.-T.; Schmidt, H.A.; Von Haeseler, A.; Minh, B.Q. IQ-TREE: A fast and effective stochastic algorithm for estimating maximum-likelihood phylogenies. Mol. Biol. Evol. 2015, 32, 268–274. [Google Scholar] [CrossRef]
- Ronquist, F.; Teslenko, M.; Van Der Mark, P.; Ayres, D.L.; Darling, A.; Höhna, S.; Larget, B.; Liu, L.; Suchard, M.A.; Huelsenbeck, J.P. MrBayes 3.2: Efficient Bayesian phylogenetic inference and model choice across a large model space. Syst. Biol. 2012, 61, 539–542. [Google Scholar] [CrossRef]
- Kalyaanamoorthy, S.; Minh, B.Q.; Wong, T.K.; Von Haeseler, A.; Jermiin, L.S. ModelFinder: Fast model selection for accurate phylogenetic estimates. Nat. Methods 2017, 14, 587–589. [Google Scholar] [CrossRef]
- Minh, B.Q.; Nguyen, M.A.T.; Von Haeseler, A. Ultrafast approximation for phylogenetic bootstrap. Mol. Biol. Evol. 2013, 30, 1188–1195. [Google Scholar] [CrossRef]
- Zhang, M.-J.; Zheng, X.-R.; Li, H.; Chen, F.-M. Alternaria alternata, the Causal Agent of a New Needle Blight Disease on Pinus bungeana. J. Fungi 2023, 9, 71. [Google Scholar] [CrossRef]
- Sutton, B.C. Fungi Imperfecti with Pycnidia, Acervuli and Stromata. In The Coelomycetes; Commonwealth Mycological Institute: London, UK, 1980. [Google Scholar]
- Von Arx, J.A. A revision of the fungi classified as Gloeosporium. In A Revision of the Fungi Classified as Gloeosporium; CAB International: Wallingford, UK, 1970. [Google Scholar]
- Huang, F.; Chen, G.; Hou, X.; Fu, Y.; Cai, L.; Hyde, K.; Li, H. Colletotrichum species associated with cultivated citrus in China. Fungal Divers. 2013, 61, 61–74. [Google Scholar] [CrossRef]
- Kim, C.H.; Hassan, O.; Chang, T. Diversity, pathogenicity, and fungicide sensitivity of Colletotrichum species associated with apple anthracnose in South Korea. Plant Dis. 2020, 104, 2866–2874. [Google Scholar] [CrossRef]
- Chen, Y.; Qiao, W.; Zeng, L.; Shen, D.; Liu, Z.; Wang, X.; Tong, H. Characterization, pathogenicity, and phylogenetic analyses of Colletotrichum species associated with brown blight disease on Camellia sinensis in China. Plant Dis. 2017, 101, 1022–1028. [Google Scholar] [CrossRef] [PubMed]
- Chen, X.; Dai, D.; Zhao, S.; Shen, Y.; Wang, H.; Zhang, C. Genetic diversity of Colletotrichum spp. causing strawberry anthracnose in Zhejiang, China. Plant Dis. 2020, 104, 1351–1357. [Google Scholar] [CrossRef]
- Cao, X.; Xu, X.; Che, H.; West, J.S.; Luo, D. Eight Colletotrichum species, including a novel species, are associated with areca palm anthracnose in Hainan, China. Plant Dis. 2020, 104, 1369–1377. [Google Scholar] [CrossRef] [PubMed]
- Zhang, Y.; Wang, J.; Yin, C.; Mao, Z.; Shao, Y. First report of Colletotrichum siamense causing Anthracnose on Jasminum mesnyi in China. Plant Dis. 2019, 103, 2675. [Google Scholar] [CrossRef]
- Zheng, X.-r.; Zhang, M.-j.; Shang, X.-l.; Fang, S.-z.; Chen, F.-m. Etiology of Cyclocarya paliurus anthracnose in Jiangsu province, China. Front. Plant Sci. 2021, 11, 613499. [Google Scholar] [CrossRef]
- Wang, Y.; Jia, W.; Zhu, X.; Mi, Z.; Wang, E.; Chang, G.; Yan, S.; Wang, X.; Kong, D.; He, S. First Report of Colletotrichum aenigma Causing Anthracnose of tree peony in China. In Plant Disease; The American Phytopathological Society (APS): St. Paul, MN, USA, 2022. [Google Scholar] [CrossRef]
- Cai, L.; Hyde, K.; Taylor, P.; Weir, B.; Waller, J.; Abang, M.; Zhang, J.; Yang, Y.; Phoulivong, S.; Liu, Z. A polyphasic approach for studying Colletotrichum. Fungal Divers. 2009, 39, 183–204. [Google Scholar]
- Costa, J.; Ramos-Sobrinho, R.; Chaves, T.; Silva, J.; Pinho, D.; Assunção, I.; Lima, G. First report of Colletotrichum fructicola causing anthracnose on Annona leaves in Brazil. Plant Dis. 2017, 101, 386. [Google Scholar] [CrossRef]
- Yuhang, Q.; Xiangrong, z.; Huan, L.; FengMao, C. First Report of Leaf Spot Caused by Colletotrichum aenigma on Acer rubrum in China. In Plant Disease; The American Phytopathological Society (APS): St. Paul, MN, USA, 2022. [Google Scholar] [CrossRef]
- Liu, F.; Weir, B.; Damm, U.; Crous, P.W.; Wang, Y.; Liu, B.; Wang, M.; Zhang, M.; Cai, L. Unravelling Colletotrichum species associated with Camellia: Employing ApMat and GS loci to resolve species in the C. gloeosporioides complex. Pers. Mol. Phylogeny Evol. Fungi 2015, 35, 63–86. [Google Scholar] [CrossRef]
- Li, F.; Chen, J.; Chen, Q.; Liu, Z.; Sun, J.; Yan, Y.; Zhang, H.; Bi, Y. Identification, Pathogenicity, and Sensitivity to Fungicide of Colletotrichum Species That Causes Walnut Anthracnose in Beijing. Agronomy 2023, 13, 214. [Google Scholar] [CrossRef]
- Wu, J.; Hu, S.; Ye, B.; Hu, X.; Xiao, W.; Yu, H.; Zhang, C. Diversity and Resistance to Thiophanate-Methyl of Colletotrichum spp. in Strawberry Nursery and the Development of Rapid Detection Using LAMP Method. Agronomy 2022, 12, 2815. [Google Scholar] [CrossRef]
- Chen, Y.; Fu, D.; Wang, W.; Gleason, M.L.; Zhang, R.; Liang, X.; Sun, G. Diversity of Colletotrichum species causing apple bitter rot and Glomerella leaf spot in China. J. Fungi 2022, 8, 740. [Google Scholar] [CrossRef]
- Xu, M.; Zhou, Y.; Zhang, R.; Zeng, Y.-C.; Zhang, Y. First report of leaf spot caused by Colletotrichum siamense on Nageia nagi in China. In Plant Disease; The American Phytopathological Society (APS): St. Paul, MN, USA, 2022. [Google Scholar] [CrossRef]
- Camiletti, B.X.; Lichtemberg, P.S.; Paredes, J.A.; Carraro, T.A.; Velascos, J.; Michailides, T.J. Characterization of Colletotrichum isolates causing Colletotrichum dieback of citrus in California. Phytopathology® 2022, 112, 1454–1466. [Google Scholar] [CrossRef]
- Verma, R.; Das, A.; Chakrawarti, N.; Narzary, P.R.; Kaman, P.; Sharma, S. First report of black pepper (Piper nigrum L.) anthracnose caused by Colletotrichum siamense in north-east India. In Plant Disease; The American Phytopathological Society (APS): St. Paul, MN, USA, 2022. [Google Scholar] [CrossRef]
- He, J.; Li, D.-W.; Bian, J.-Y.; Zhu, L.-H.; Huang, L. Unravelling species diversity and pathogenicity of Colletotrichum associated with anthracnose on Osmanthus fragrans in Quanjiao, China. Plant Dis. 2023, 107, 350–362. [Google Scholar] [CrossRef] [PubMed]
- Huang, R.; Gui, Q.; Zhang, Y.; Sun, W.; Tang, L.; Huang, S.; Guo, T.; Li, Q.; Mo, J.; Huang, H. Identification and Observation of Infection Processes of Colletotrichum Species Associated with Pearl Plum Anthracnose in Guangxi, China. Plant Dis. 2022, 106, 3154–3165. [Google Scholar] [CrossRef] [PubMed]
- Wang, X.; Liu, X.; Wang, R.; Fa, L.; Chen, L.; Xin, X.; Zhang, Y.; Tian, H.; Xia, M.; Hou, X. First report of Colletotrichum aenigma causing walnut anthracnose in China. Plant Dis. 2021, 105, 225. [Google Scholar] [CrossRef]
- Zhang, Z.; Yan, M.; Li, W.; Guo, Y.; Liang, X. First Report of Colletotrichum aenigma Causing Apple Glomerella Leaf Spot on the Granny Smith Cultivar in China. Plant Dis. 2021, 105, 1563. [Google Scholar] [CrossRef]
- Gunjan, S.; Marcel, M.; Meirav, E.; Stanley, F. First report of Colletotrichum aenigma and C. perseae causing anthracnose disease on Capsicum annuum in Israel. Crop Prot. 2022, 152, 105853. [Google Scholar] [CrossRef]
- Hofer, K.M.; Braithwaite, M.; Braithwaite, L.J.; Sorensen, S.; Siebert, B.; Pather, V.; Goudie, L.; Williamson, L.; Alexander, B.J.; Toome-Heller, M. First report of Colletotrichum fructicola, C. perseae, and C. siamense causing anthracnose disease of avocado (Persea americana) in New Zealand. Plant Dis. 2021, 105, 1564. [Google Scholar] [CrossRef] [PubMed]
- Alam, M.W.; Malik, A.; Rehman, A.; Hameed, A.; Tahir, U.; Sarwar, M.; Hussain, M.; Hussain, D.; Shafeeq, T. First record of Colletotrichum gloeosporioides causing anthracnose of banana in Pakistan. Plant Dis. 2021, 105, 2013. [Google Scholar] [CrossRef] [PubMed]
- Slippers, B.; Stenlid, J.; Wingfield, M.J. Emerging pathogens: Fungal host jumps following anthropogenic introduction. Trends Ecol. Evol. 2005, 20, 420–421. [Google Scholar] [CrossRef] [PubMed]

| Gene | Primer | Sequence (5′-3′) | PCR Conditions | References |
|---|---|---|---|---|
| Internal transcribed spacer (ITS) | ITS1 | CTTGGTCATTTAGAGGAAGTAA | Denaturation for 4 min at 95 °C, followed by 35 cycles of 30 s at 95 °C, 30 s at 52 °C, and 45 s at 72 °C, with a final extension of 7 min at 72 °C | [41,42] |
| ITS4 | TCCTCCGCTTATTGATATGC | |||
| Calmodulin (CAL) | CL1C | GAATTCAAGGAGGCCTTCTC | Denaturation for 4 min at 95 °C, followed by 35 cycles of 30 s at 95 °C, 30 s at 59 °C, and 45 s at 72 °C, with a final extension of 7 min at 72 °C | [20] |
| CL2C | CTTCTGCATCATGAGCTGGAC | |||
| Glyceraldehyde-3-phosphate dehydrogenase (GAPDH) | GDF | GCCGTCAACGACCCCTTCATTGA | Denaturation for 4 min at 95 °C, followed by 35 cycles of 30 s at 95 °C, 30 s at 60 °C, and 45 s at 72 °C, with a final extension of 7 min at 72 °C | [43] |
| GDR | GGGTGGAGTCGTACTTGAGCATGT | |||
| β-tubulin (TUB2) | T1 | AACATGCGTGAGATTGTAAGT | Denaturation for 4 min at 95 °C, followed by 35 cycles of 30 s at 95 °C, 30 s at 55 °C, and 45 s at 72 °C, with a final extension of 7 min at 72 °C | [44,45] |
| Bt2b | ACCCTCAGTGTAGTGACCCTTGGC | |||
| Actin (ACT) | ACT-512F | ATGTGCAAGGCCGGTTTCGC | Denaturation for 4 min at 95 °C, followed by 35 cycles of 30 s at 95 °C, 30 s at 58 °C, and 45 s at 72 °C, with a final extension of 7 min at 72 °C | [46] |
| ACT-783R | TACGAGTCCTTCTGGCCCAT | |||
| Chitin synthase 1 (CHS-1) | CHS-79F | TGGGGCAAGGATGCTTGGAAGAAG | Denaturation for 4 min at 95 °C, followed by 35 cycles of 30 s at 95 °C, 30 s at 58 °C, and 45 s at 72 °C, with a final extension of 7 min at 72 °C | [46] |
| CHS-345R | TGGAAGAACCATCTGTGAGAGTTG | |||
| Glutamine synthetase (GS) | GSF | ATGGCCGAGTACATCTGG | Denaturation for 4 min at 95 °C, followed by 35 cycles of 30 s at 95 °C, 30 s at 59 °C, and 45 s at 72 °C, with a final extension of 7 min at 72 °C | [47] |
| GSR | GAACCGTCGAAGTTCCAC | |||
| Apn2- Mat1-2 intergenic spacer (ApMat) | CgDL-F6 | AGTGGAGGTGCGGGACGTT | Denaturation for 4 min at 95 °C, followed by 35 cycles of 30 s at 95 °C, 30 s at 58 °C, and 45 s at 72 °C, with a final extension of 7 min at 72 °C | [48] |
| CgMAT1F2 | TGATGTATCCCGACTACCG |
| Groups/Isolates | Conidia | Appressoria | Ascospore |
|---|---|---|---|
| XZEC11 | 14.0–18.3 × 5.5–7.8 | 6.8–12.1 × 5.4–8.1 | 14.1–16.9 × 4.4–6.0 |
| XZEC21 | 11.1–14.8 × 3.6–5.7 | 7.1–11.0 × 5.7–8.4 | 19.0–21.8 × 3.7–4.9 |
| XZEC31 | 12.9–17.5 × 5.4–7.3 | 7.0–12.5 × 4.8–8.6 | —— |
| XZEC41 | 12.2–18.6 × 3.8–5.7 | 6.3–12.3 × 5.0–8.3 | —— |
| Species, (Culture/Isolate Number a) | Country, Host | GenBank Accession Number b | |||||||
|---|---|---|---|---|---|---|---|---|---|
| ITS | CAL | GAPDH | TUB2 | ACT | CHS-1 | GS | ApMat | ||
| C. aenigma (ICMP 18608) | Israel, Persea americana | JX010244 | JX009683 | JX010044 | JX010389 | JX009443 | JX009774 | JX010078 | KM360143 |
| C. aenigma (ICMP 18686) | Japan, Pyrus pyrifolia | JX010243 | JX009684 | JX009913 | JX010390 | JX009519 | JX009789 | JX010079 | — |
| C. aenigma (XZEC31 c) | China, Carpinus betulus | OQ352860 | OQ427912 | OQ427918 | OQ427921 | OQ427909 | OQ427915 | OQ695544 | OQ695541 |
| C. aenigma (XZEC32) | China, C. betulus | OQ352861 | OQ427913 | OQ427919 | OQ427922 | OQ427910 | OQ427916 | OQ695545 | OQ695542 |
| C. aenigma (XZEC33) | China, C. betulus | OQ352862 | OQ427914 | OQ427920 | OQ427923 | OQ427911 | OQ427917 | OQ695546 | OQ695543 |
| C. aeschynomenes (ICMP 17673) | USA, Aeschynomene virginica | JX010176 | JX009721 | JX009930 | JX010392 | JX009483 | JX009799 | JX010081 | — |
| C. alatae (CBS 304.67) | India, Dioscorea alata | JX010190 | JX009738 | JX009990 | JX010383 | JX009471 | JX009837 | JX010065 | KC888932 |
| C. alatae (ICMP 18122) | Nigeria, Dioscorea alata | JX010191 | JX009739 | JX010011 | JX010449 | JX009470 | JX009846 | JX010136 | — |
| C. alienum (ICMP 18691) | Australia, Persea americana | JX010217 | JX009664 | JX010018 | JX010385 | JX009580 | JX009754 | JX010074 | — |
| C. alienum (ICMP 12071) | New Zealand, Malus domestica | JX010251 | JX009654 | JX010028 | JX010411 | JX009572 | JX009882 | JX010101 | KM360144 |
| C. alienum (ICMP 18621) | New Zealand, Persea americana | JX010246 | JX009657 | JX009959 | JX010386 | JX009552 | JX009755 | JX010075 | — |
| C. asianum (ICMP 18696) | Australia, Mangifera indica | JX010192 | JX009723 | JX009915 | JX010384 | JX009576 | JX009753 | JX010073 | — |
| C. asianum (ICMP 18580) | Thailand, Coffea arabica | FJ972612 | FJ917506 | JX010053 | JX010406 | JX009584 | JX009867 | JX010096 | FR718814 |
| C. chrysophilum (AFK22) | USA, Apple/Honeycrisp | MN625456 | MN622857 | MN632505 | MN622866 | — | — | MN622843 | MN622875 |
| C. chrysophilum (C53, L53) | Uruguay, Apple/Galaxy | MZ562285 | MZ562249 | MG491675 | MG491716 | — | — | MZ562258 | MZ562276 |
| C. chrysophilum (CMM 4352) | Brazil, Musa sp. | KX094254 | KX094064 | KX094184 | KX094286 | — | — | KX094205 | KX094326 |
| C. chrysophilum (MANE 5) | Brazil, Apple/Gala | KT806271 | MZ595288 | KT806294 | KT806281 | — | — | MZ595299 | MZ595266 |
| C. fructicola (ICMP 18120) | Nigeria, Dioscorea alata | JX010182 | JX009670 | JX010041 | JX010401 | JX009436 | JX009844 | JX010091 | — |
| C. fructicola (CBS 125395) | Panama, Theobroma cacao | JX010172 | JX009666 | JX009992 | JX010408 | JX009543 | JX009873 | JX010098 | — |
| C. fructicola (ICMP 18581) | Thailand, Coffea arabica | JX010165 | FJ917508 | JX010033 | JX010405 | FJ907426 | JX009866 | JX010095 | JQ807838 |
| C. fructicola (ICMP 18727) | USA, Fragaria × ananassa | JX010179 | JX009682 | JX010035 | JX010394 | JX009565 | JX009812 | JX010083 | — |
| C. fructicola (XZEC21 c) | China, C. betulus | OQ352857 | OQ427882 | OQ427888 | OQ427891 | OQ427879 | OQ427885 | OQ695538 | OQ695535 |
| C. fructicola (XZEC22) | China, C. betulus | OQ352858 | OQ427883 | OQ427889 | OQ427892 | OQ427880 | OQ427886 | OQ695539 | OQ695536 |
| C. fructicola (XZEC23) | China, C. betulus | OQ352859 | OQ427884 | OQ427890 | OQ427893 | OQ427881 | OQ427887 | OQ695540 | OQ695537 |
| C. gloeosporioides (IMI 356878) | Italy, Citrus sinensis | JX010152 | JX009731 | JX010056 | JX010445 | JX009531 | JX009818 | JX010085 | JQ807843 |
| C. gloeosporioides (ICMP 12939) | New Zealand, Citrus sp. | JX010149 | JX009728 | JX009931 | — | JX009462 | JX009747 | — | — |
| C. gloeosporioides (ICMP 12066) | New Zealand, Ficus sp. | JX010158 | JX009734 | JX009955 | — | JX009550 | JX009888 | — | — |
| C. gloeosporioides (ICMP 18730) | New Zealand, Citrus sp. | JX010157 | JX009737 | JX009981 | — | JX009548 | JX009861 | — | — |
| C. gloeosporioides (ICMP 18678) | USA, Pueraria lobata | JX010150 | JX009733 | JX010013 | — | JX009502 | JX009790 | — | — |
| C. gloeosporioides (XZEC11 c) | China, C. betulus | OQ352863 | OQ427897 | OQ427903 | OQ427906 | OQ427894 | OQ427900 | OQ695532 | OQ695529 |
| C. gloeosporioides (XZEC12) | China, C. betulus | OQ352864 | OQ427898 | OQ427904 | OQ427907 | OQ427895 | OQ427901 | OQ695533 | OQ695530 |
| C. gloeosporioides (XZEC13) | China, C. betulus | OQ352865 | OQ427899 | OQ427905 | OQ427908 | OQ427896 | OQ427902 | OQ695534 | OQ695531 |
| C. hippeastri (CBS 241.78) | The Netherlands, Hippeastrum sp. | JX010293 | JX009740 | JX009932 | — | JX009485 | JX009838 | — | — |
| C. horii (ICMP 12942) | New Zealand, Diospyros kaki | GQ329687 | JX009603 | GQ329685 | JX010375 | JX009533 | JX009748 | JX010072 | — |
| C. horii (NBRC 7478) | Japan, Diospyros kaki | GQ329690 | JX009604 | GQ329681 | JX010450 | JX009438 | JX009752 | JX010137 | — |
| C. horii (ICMP 17968) | China, Diospyros kaki | JX010212 | JX009605 | GQ329682 | JX010378 | JX009547 | JX009811 | JX010068 | — |
| C. musae (IMI 52264) | Kenya, Musa sapientum | JX010142 | JX009689 | JX010015 | JX010395 | JX009432 | JX009815 | JX010084 | — |
| C. musae (CBS 116870) | USA, Musa sp. | JX010146 | JX009742 | JX010050 | HQ596280 | JX009433 | JX009896 | JX010103 | KC888926 |
| C. noveboracense (AFKH109) | USA, Apple/Idared | MN646685 | MN640566 | MN640567 | MN640569 | — | — | MN640568 | MN640564 |
| C. noveboracense (PMBrms-1) | USA, Apple | MN715324 | MN741056 | MN741087 | MN741064 | — | — | MN741100 | MN741075 |
| C. nupharicola (CBS 469.96) | USA, Nuphar lutea subsp. Polysepala | JX010189 | JX009661 | JX009936 | JX010397 | JX009486 | JX009834 | JX010087 | — |
| C. nupharicola (CBS 470.96) | USA, Nuphar lutea subsp. Polysepala | JX010187 | JX009663 | JX009972 | JX010398 | JX009437 | JX009835 | JX010088 | JX145319 |
| C. queenslandicum (ICMP 1778) | Australia, Carica papaya | JX010276 | JX009691 | JX009934 | JX010414 | JX009447 | JX009899 | JX010104 | KC888928 |
| C. queenslandicum (ICMP 18705) | Fiji, Coffea sp. | JX010185 | JX009694 | JX010036 | JX010412 | JX009490 | JX009890 | JX010102 | — |
| C. salsolae (ICMP 19051) | Hungary, Salsola tragus | JX010242 | JX009696 | JX009916 | JX010403 | JX009562 | JX009863 | JX010093 | KC888925 |
| C. salsolae (CBS 119296) | Hungary, Glycine max (inoculated) | JX010241 | JX009695 | JX009917 | — | JX009559 | JX009791 | — | — |
| C. siamense (ICMP 18578) | Thailand, Coffea arabica | JX010171 | FJ917505 | JX009924 | JX010404 | FJ907423 | JX009865 | JX010094 | — |
| C. siamense (ICMP 17795) | USA, Malus domestica | JX010162 | JX009703 | JX010051 | JX010393 | JX009506 | JX009805 | JX010082 | — |
| C. siamense (XZEC41 c) | China, C. betulus | OQ352866 | OQ427927 | OQ427933 | OQ427936 | OQ427924 | OQ427930 | OQ695549 | OQ695547 |
| C. siamense (XZEC42) | China, C. betulus | OQ352867 | OQ427928 | OQ427934 | OQ427937 | OQ427925 | OQ427931 | OQ695550 | OQ695548 |
| C. theobromicola (ICMP 17895) | Mexico, Annona diversifolia | JX010284 | JX009600 | JX010057 | JX010382 | JX009568 | JX009828 | JX010066 | — |
| C. theobromicola (CBS 124945) | Panama, Theobroma cacao | JX010294 | JX009591 | JX010006 | JX010447 | JX009444 | JX009869 | JX010139 | KC790726 |
| C. tropicale (MAFF 239933) | Japan, Litchi chinensis | JX010275 | JX009722 | JX010020 | JX010396 | JX009480 | JX009826 | JX010086 | — |
| C. tropicale (CBS 124949) | Panama, Theobroma cacao | JX010264 | JX009719 | JX010007 | JX010407 | JX009489 | JX009870 | JX010097 | KC790728 |
| C. xanthorrhoeae (BRIP 45094) | Australia, Xanthorrhoea preissii | JX010261 | JX009653 | JX009927 | JX010448 | JX009478 | JX009823 | JX010138 | KC790689 |
| C. xanthorrhoeae (ICMP 17820) | Australia, Xanthorrhoea sp. | JX010260 | JX009652 | JX010008 | — | JX009479 | JX009814 | — | — |
Disclaimer/Publisher’s Note: The statements, opinions and data contained in all publications are solely those of the individual author(s) and contributor(s) and not of MDPI and/or the editor(s). MDPI and/or the editor(s) disclaim responsibility for any injury to people or property resulting from any ideas, methods, instructions or products referred to in the content. |
© 2023 by the authors. Licensee MDPI, Basel, Switzerland. This article is an open access article distributed under the terms and conditions of the Creative Commons Attribution (CC BY) license (https://creativecommons.org/licenses/by/4.0/).
Share and Cite
Qiao, Y.-H.; Zhang, C.-N.; Li, M.; Li, H.; Mao, Y.-F.; Chen, F.-M. Species of the Colletotrichum spp., the Causal Agents of Leaf Spot on European Hornbeam (Carpinus betulus). J. Fungi 2023, 9, 489. https://doi.org/10.3390/jof9040489
Qiao Y-H, Zhang C-N, Li M, Li H, Mao Y-F, Chen F-M. Species of the Colletotrichum spp., the Causal Agents of Leaf Spot on European Hornbeam (Carpinus betulus). Journal of Fungi. 2023; 9(4):489. https://doi.org/10.3390/jof9040489
Chicago/Turabian StyleQiao, Yu-Hang, Chen-Ning Zhang, Min Li, Huan Li, Yun-Fei Mao, and Feng-Mao Chen. 2023. "Species of the Colletotrichum spp., the Causal Agents of Leaf Spot on European Hornbeam (Carpinus betulus)" Journal of Fungi 9, no. 4: 489. https://doi.org/10.3390/jof9040489
APA StyleQiao, Y.-H., Zhang, C.-N., Li, M., Li, H., Mao, Y.-F., & Chen, F.-M. (2023). Species of the Colletotrichum spp., the Causal Agents of Leaf Spot on European Hornbeam (Carpinus betulus). Journal of Fungi, 9(4), 489. https://doi.org/10.3390/jof9040489

